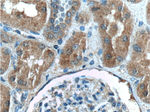
C8orf4 Antibody in Immunohistochemistry (Paraffin) (IHC (P))
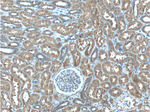
C8orf4 Antibody in Immunohistochemistry (Paraffin) (IHC (P))

Search
Proteintech
C8orf4 Polyclonal Antibody
{{$productOrderCtrl.translations['antibody.pdp.commerceCard.promotion.promotions']}}
{{$productOrderCtrl.translations['antibody.pdp.commerceCard.promotion.viewpromo']}}
{{$productOrderCtrl.translations['antibody.pdp.commerceCard.promotion.promocode']}}: {{promo.promoCode}} {{promo.promoTitle}} {{promo.promoDescription}}. {{$productOrderCtrl.translations['antibody.pdp.commerceCard.promotion.learnmore']}}
产品信息
26279-1-AP
种属反应
宿主/亚型
分类
类型
抗原
偶联物
形式
浓度
规格
纯化类型
保存液
内含物
保存条件
运输条件
产品详细信息
Immunogen sequence: MKAKRSHQA IIMSTSLRVS PSIHGYHFDT ASRKKAVGNI FENTDQESLE RLFRNSGDKK AEERAKIIFA IDQDVEEKTR ALMALKKRTK DKLFQFLKLR KYSIKVH (1-106 aa encoded by BC021672)
靶标信息
This gene encodes a small, monomeric, predominantly unstructured protein that functions as a positive regulator of the Wnt/beta-catenin signaling pathway. This protein interacts with a repressor of beta-catenin mediated transcription at nuclear speckles. It is thought to competitively block interactions of the repressor with beta-catenin, resulting in up-regulation of beta-catenin target genes. The encoded protein may also play a role in the NF-kappaB and ERK1/2 signaling pathways. Expression of this gene may play a role in the proliferation of several types of cancer including thyroid cancer, breast cancer and hematological malignancies.
仅用于科研。不用于诊断过程。未经明确授权不得转售。
篇参考文献 (0)
生物信息学
蛋白别名: human thyroid cancer 1; protein C8orf4; TC-1; Thyroid cancer protein 1; thyroid cancer-1; Transcriptional and immune response regulator; uncharacterized protein C8orf4 homolog
基因别名: 1110065B09Rik; AW121743; AW321058; C8orf4; TC-1; TC1; TCIM
UniProt ID: (Mouse) Q9D915, (Human) Q9NR00
Entrez Gene ID: (Mouse) 69068, (Human) 56892